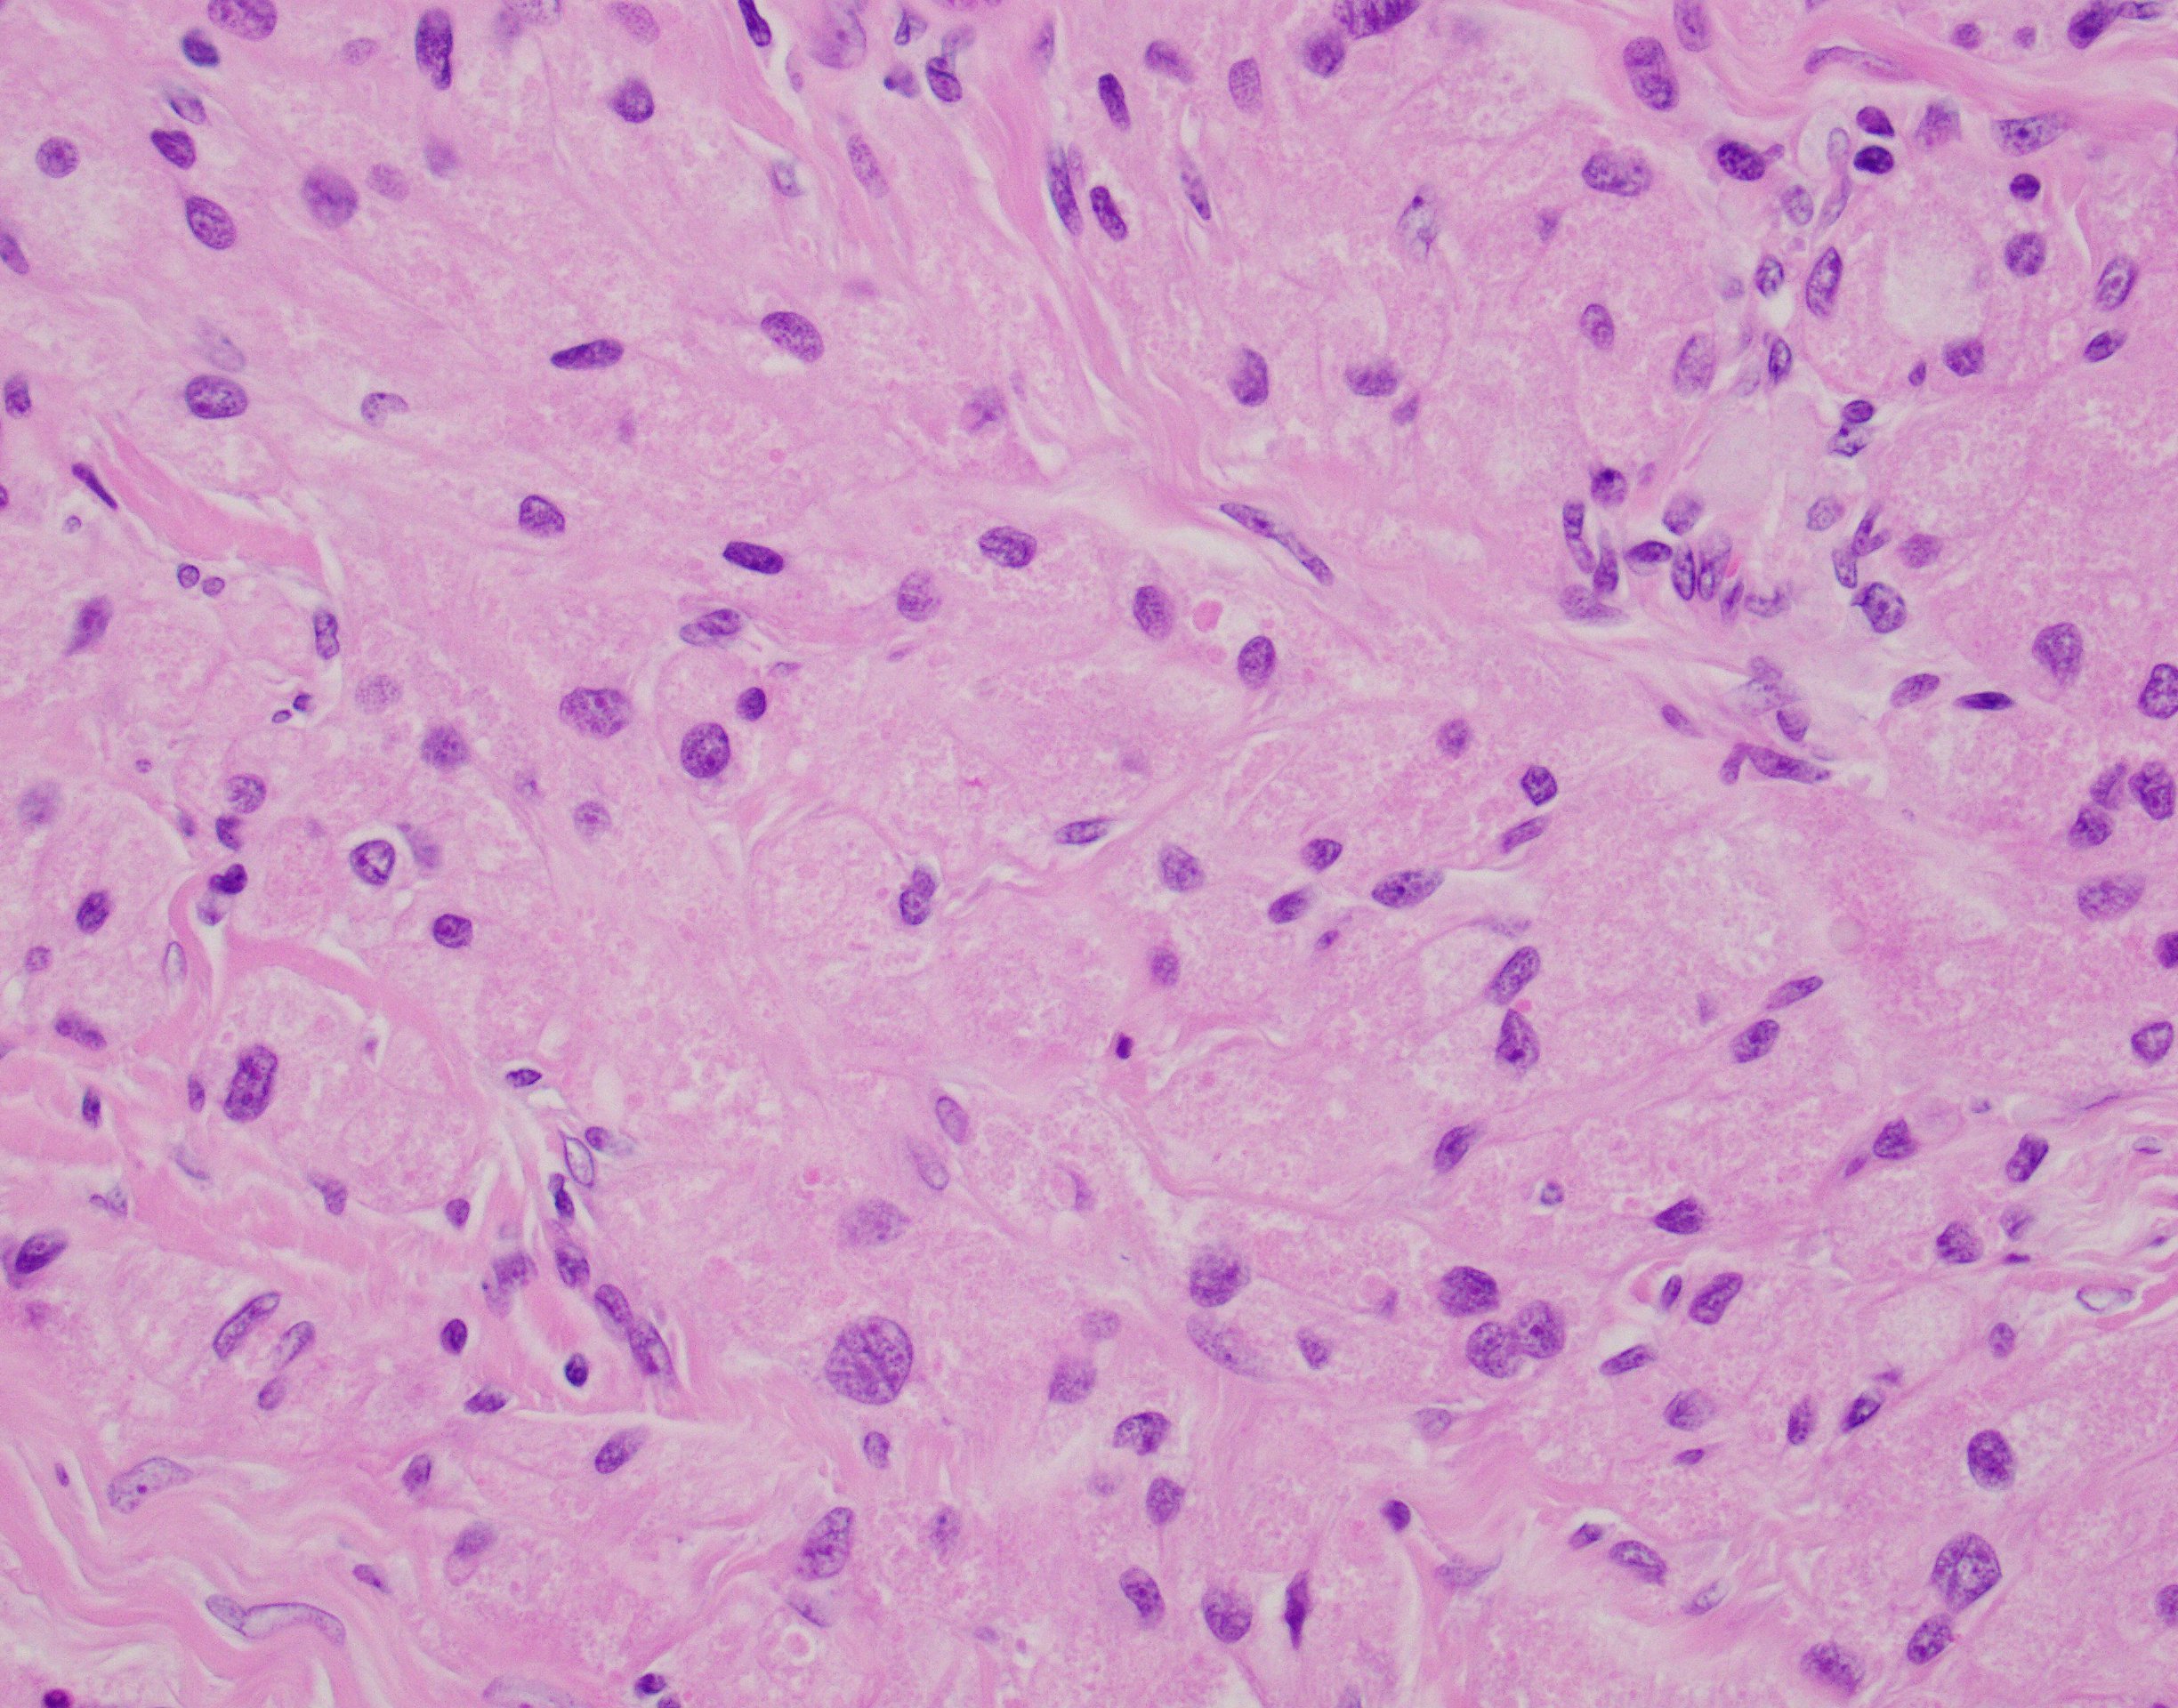

Case History
29-year old male with a 4.7 cm gastric mass. The immunoprofile of this tumor is CD117 -, DOG1 -, Sox10 + and CD68 +.
What is the diagnosis?
- Gastrointestinal Stromal Tumor (GIST)
- Leiomyoma
- Granular Cell Tumor (GCT)
- Malignant Gastrointestinal Neuroectodermal Tumor (MGINT) AKA “clear cell sarcoma-like tumor of the gastrointestinal tract”

The answer is “C”, Granular Cell Tumor (GCT) (Example “A”, Granular cell tumor)
A brief explanation of the answer and summary of the histomorpholgoic findings, immunohistochemistry, clinical presentation, and other pertinent information needed to make the diagnosis.
Granular cell tumors from the GI tract are relatively uncommon and comprise approximately 4% to 6% of all GCTs with the stomach GCT being the least common location while esophagus and colorectal being the most common GI tract sites. GCTs are neural crest derived lesions that express both S100 and Sox10 in addition to lysosomal markers such as CD68 (the lesional cells’ cytoplasm is packed with these structures giving them their characteristic appearance). The exceedingly rare examples of GCT might show a combination of the following features: highly infiltrative borders, necrosis, spindling, high N:C ratio, vesicular nuclei with large nucleoli, nuclear pleomorphism, increased mitotic activity (more than 2 mitoses/10 high-power fields) and/or increased proliferative index by Ki-67 (> 10%). None of these features were present in the presented case.
- GISTs will express CD117 and/or DOG1 and in the stomach often show spindle cell morphology with a paranuclear cytoplasmic vacuole.
- Leiomyomas are composed of interconnecting fascicles of spindle cells with eosinophilic cytoplasm and cigar-shaped nuclei.
D. MGINT/CSS-like tumor of the GI tract is a relatively newly described GI tract sarcoma with neural crest differentiation. MGINT lesions harbor the same EWSR1/FUS-ATF1/CREB1 gene fusions see in in CSS of the soft tissue but invariably lack expression of melanocytic markers. Although can rarely exhibit oncocytic change, by definition it shows frankly malignant histomorphology and clinical behavior.
References
An S, Jang J, Min K, Kim MS, Park H, Park YS, Kim J, Lee JH, Song HJ, Kim KJ, Yu E, Hong SM. Granular cell tumor of the gastrointestinal tract: histologic and immunohistochemical analysis of 98 cases. Hum Pathol. 2015 Jun;46(6):813-9. doi: 10.1016/j.humpath.2015.02.005. Epub 2015 Feb 26. PMID: 25882927.
Boland JM, Folpe AL. Oncocytic variant of malignant gastrointestinal neuroectodermal tumor: a potential diagnostic pitfall. Hum Pathol. 2016 Nov;57:13-16. doi: 10.1016/j.humpath.2016.05.026. Epub 2016 Jun 23. PMID: 27346570.